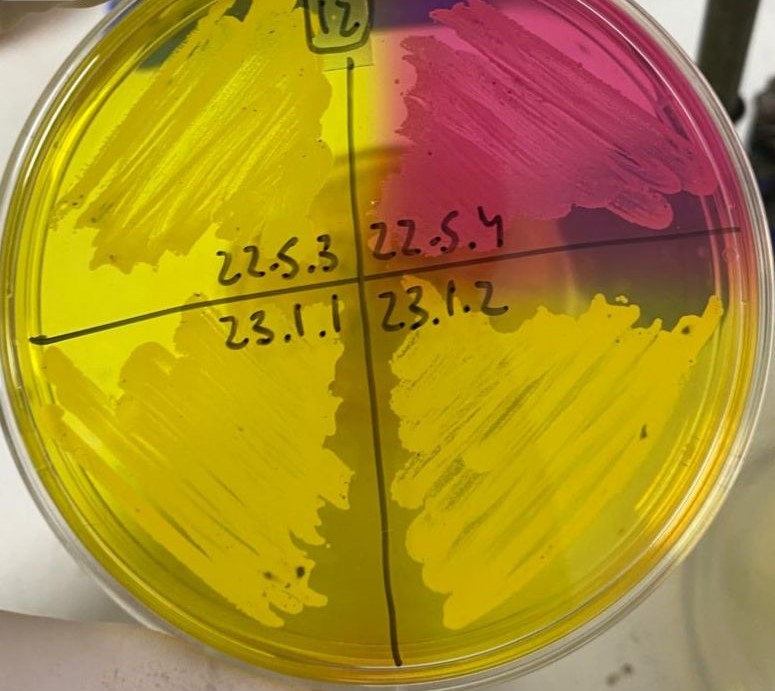
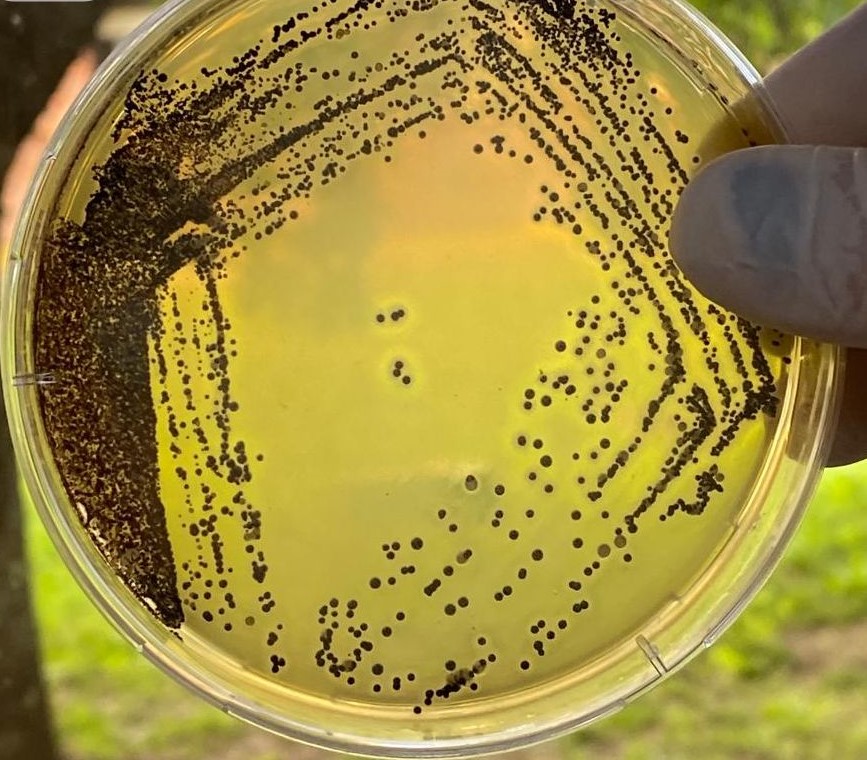

Un grupo interdisciplinario del Centro de Investigación Veterinaria de Tandil (CIVETAN) y la Universidad Nacional del Centro de la Provincia (UNICEN) estudia pequeños emprendimientos comunitarios o familiares que elaboran alimentos de forma artesanal, con el objetivo de que puedan alcanzar estándares más altos de seguridad alimentaria.
El proyecto está financiado por la Comisión de Investigaciones Científicas (CIC), a través de la convocatoria Ideas-Proyecto y se apoya sobre un trabajo previo realizado por este mismo equipo entre 2021 y 2023 en el marco de la convocatoria “Argentina contra el Hambre”, en el cual se desarrolló un programa piloto de acompañamiento de Pequeñas Unidades Productivas de Alimentos Artesanales (PUPAAs) de la región de Tandil.
Se trata de pequeños emprendimientos que elaboran panificados, confituras, dulces, embutidos, conservas, miel, entre otros productos. Por el tamaño, la escala y otras características de estos espacios de trabajo, no están en condiciones de afrontar las exigencias y requisitos de habilitación e inscripción de productos que establece el Código Alimentario Argentino. Pero de todas formas necesitan optimizar y garantizar la seguridad de sus procesos de producción y ahí es donde aparece la vinculación con el sistema científico tecnológico bonaerense.

“Apuntamos a que las personas elaboren alimentos de manera segura e inocua, por eso el proyecto contempla capacitaciones contínuas para evitar el desarrollo de enfermedades transmitidas por alimentos en las personas que los consumen”, explicó la Dra en Ciencia Animal Juliana González, integrante del equipo. Este tipo de productos cuentan con la ventaja de tener un bajo riesgo microbiológico y no necesitar una cadena de frío posterior para ser conservados o comercializados.
El proyecto tiene un impacto directo en la producción regional, tanto en términos económicos como sociales. “Estos alimentos no sólo son elaborados de manera domiciliaria sino que en general son hechos con productos que se obtienen regionalmente. No son grandes industrias las que están detrás. Hay una circulación de lo que es capital a nivel local, y genera un ingreso para estas familias que en general son vulneradas o están en situaciones vulnerables. Y mayormente son mujeres quienes están a cargo de los emprendimientos”, detalló.

El grupo de trabajo reúne diversas disciplinas, intervienen profesionales en tecnología de los alimentos, trabajo social, ciencia animal, comunicación, gestión de la economía social y solidaria y gestión de sistemas de finanzas solidarias. A su vez, mantienen una coordinación estrecha con la Dirección de Industrias y Productos Alimenticios del Ministerio de Desarrollo Agrario de la Provincia, que les ha permitido, entre otras cosas, concretar procesos de habilitación de establecimientos que funcionan en los propios domicilios de las emprendedoras o emprendendores.
Disminuir el riesgo de aparición de ETA
El objetivo de controlar la inocuidad de los alimentos es disminuir el riesgo de aparición de las enfermedades que éstos pueden transmitir, denominadas ETA (enfermedades de transmisión de los alimentos). “Las mismas constituyen una importante causa de morbilidad y mortalidad en todo el mundo y afectan a personas de todas las edades”, remarcan desde el equipo de investigación.
Entre los principales patógenos productores de ETA en nuestro país, se destacan Escherichia coli, productor de toxina Shiga (STEC), que ocasiona enfermedades graves como colitis hemorrágica y síndrome urémico hemolítico (SUH); Salmonella spp, que puede causar fiebres entéricas, gastroenteritis, bacteriemia o infecciones localizadas; y Staphylococcus aureus, que puede producir intoxicaciones u otras patologías..
Este proyecto cobra relevancia también porque hasta el momento son escasos los estudios desarrollados respecto de la incidencia y caracterización de bacterias productoras de ETA a nivel de emprendimientos comunitarios de elaboración artesanal de alimentos.

Un manual de uso masivo
Para el desarrollo de la investigación, el equipo utiliza herramientas de diagnóstico situacional, monitoreo microbiológico, caracterización feno-genotípica de las bacterias patógenas halladas e identificación de prácticas asociadas a la presencia de bacterias.
“Antes de convocar a cada emprendimiento lo que hacemos es un acuerdo de confidencialidad. Todos los datos que obtenemos son confidenciales y se devuelven a cada emprendedor, y después lo publicamos de manera anónima, en conjunto”, afirmó González.
El equipo de investigación visita los emprendimientos, desarrolla un checklist identificando factores de riesgo vinculados a las instalaciones, revisa la manera en que se elabora la comida, las materias primas y se lleva muestras del ambiente, las superficies y los alimentos que se elaboran. “En el laboratorio hacemos recuentos microbiológicos que dan cuenta de la calidad de ese alimento y del ambiente donde es elaborado”, indicó la investigadora.

No sólo realizan después una devolución a cada unidad productiva, sino que paralelamente elaboraron un manual de buenas prácticas, que está a punto de ser publicado. “La idea era que esta experiencia sirva para utilizar en otros lugares también y poder pasar el manual para un uso masivo, porque es un material muy accesible. La intención no era hacer un trabajo de investigación que quede sólo en eso, por más que se trate de investigación aplicada, si no que sirva de información para otras regiones”, apuntó la Dra en Ciencia Animal Nora Padola, directora del proyecto.
Por David Barresi